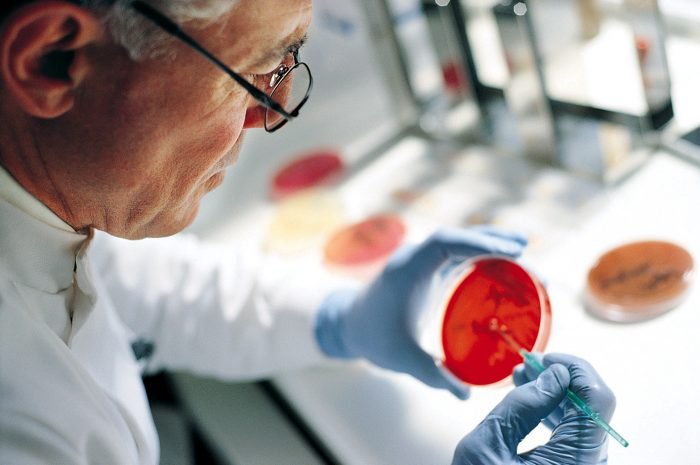
Диагностика

Острый миелоидный лейкоз – не приговор!

Острый миелоидный лейкоз – не приговор!
Острый миелоидный лейкоз – это злокачественное заболевание кроветворной системы, которое, как правило, возникает у детей младше 15 или пожилых старше 60 лет. Здесь о причинах развития этого заболевания, его признаках, способах и перспективах лечения.
Что такое миелолейкоз?

Острый миелоидный лейкоз (лейкемия, белокровие) развивается вследствие мутации кроветворных клеток миелоидного ростка костного мозга.
В отличие от лимфобластного типа лейкемии, при миелоидном белокровии мутировать могут не только предшественники лейкоцитов, но и бластные клетки, которые при нормальном развитии развиваются в эритроциты и тромбоциты. В большинстве случаев ОМЛ наблюдается бесконтрольная пролиферация именно белых кровяных телец, что обуславливает второе название болезни (белокровие).
Несмотря на то, что мутации может подвергнуться любая из кроветворных клеток, симптоматика болезни является практически единой. Это обусловлено общим механизмом развития лейкемии.
Бесконтрольно пролиферирующие незрелые бласты активно вытесняют функциональные клетки других кроветворных ростков, вызывая (в зависимости от типа лейкоза) тромбоцитопению, анемию и снижение иммунитета. Однако сами мутировавшие клетки-предшественницы не в состоянии выполнять свои функции из-за малой степени зрелости.
Это приводит к тому, что при любом из видов лейкемии наблюдается снижение количество эритроцитов, тромбоцитов и функциональных иммунных клеток – лейкоцитов.
Острый миелоидный лейкоз, как правило, развивается у пожилых пациентов: риск его проявления резко повышается у людей старше 50 лет, а средний возраст больного ОМЛ составляет 63 года. В старшей и младшей (до 15 лет) возрастной группе заболеваемости преобладают мужчины, в молодом и среднем возрасте различий в рисках по половому признаку не наблюдается.
Причины развития миелоидной лейкемии
Точные причины, гарантированно приводящие к развития миелоидной лейкемии, не установлены. Однако гематологи и онкологи выделяют ряд факторов, которые значительно повышают риск возникновения этого заболевания крови. К ним относят:
- пре-лейкозные патологии кроветворения (миелодиспластический и миелопролиферативный синдромы на фоне характерных цитогенетических изменений, ПНГ и др.);
- применение противораковых препаратов по поводу другого онкологического заболевания (высокие риски несёт применение антрациклинов и алкилирующих веществ);
- длительный контакт с химическими канцерогенами (фенилфутазоном, соединениями мышьяка, хлорамфениколом, толуолом, бензолом и др.);
- ионизирующее излучение;
- наследственная предрасположенность (наличие болезни у близких родственников) и наличие хромосомных патологий, ассоциированных с повышенным риском ОМЛ (синдром Дауна, сбалансированные и несбалансированные аномалии на участках хромосом, характерные генные мутации).

Острый миелоидный лейкоз лекарственного происхождения составляет до 20% всех клинических случаев мутации клеток миелоидного ростка. Как правило, эта патология возникает в течение 3-5 лет после окончания химиотерапии по поводу другого онкологического заболевания.
Воздействие химических канцерогенов проявляется в течение 1-5 лет после контакта с ними. Специалисты указывают на то, что этот контакт с вредными реактивами усиливает негативное воздействие других факторов риска, однако редко является единственной причиной развития ОМЛ.
По данным некоторых исследований, курение также увеличивает шансы развития острого лейкоза. Прогнозы пятилетней выживаемости и средняя длительность полных ремиссий у курящих пациентов хуже, чем у некурящих.
Симптомы острого миелолейкоза
Клиническая картина миелоидной лейкемии схожа с симптоматикой лимфобластного лейкоза. При мутации кроветворных клеток миелоидного ростка также наблюдается анемический, геморрагический, интоксикационный и инфекционный синдромы.
Однако пролиферативный синдром имеет ряд особенностей: например, при ОМЛ отсутствуют выраженные изменения объёма периферических лимфоузлов, печени и селезёнки. В некоторых случаях выявляют увеличение надключичных и шейных ЛУ, другие же остаются небольшими и подвижными.
Инфильтрация организма незрелыми клетками крови проявляется в костях и суставах. Больные жалуются на боли в позвоночнике и костях нижних конечностей, их движения ограничиваются, а походка меняется. Нередко распространение лейкозных клеток проявляется экзофтальмом (выпячиванием глазного яблока), набуханием и воспалением дёсен без нарушения их целостности, увеличением миндалин.
Анемия, вызванная недостатком красных кровяных телец, проявляется бледностью кожи и слизистых пациента (иногда они могут приобретать землистый оттенок), постоянной слабостью, головокружением, повышением частоты сердечных сокращений и одышкой.
Тромбоцитопения провоцирует повышенную кровоточивость, появление геморрагической сыпи, крупных гематом. Кровоизлияния могут наблюдаться как снаружи (из дёсен, носа и при повреждениях кожи), так и внутри. Внутренние кровотечения фиксируются по примесям крови в моче (гематурия), рвоте и кале.
Несмотря на малое количество тромбоцитов, вязкость крови может сохраняться и даже повышаться из-за бурной пролиферации мутантных клеток. Высокая вязкость крови может спровоцировать инфаркты и кровоизлияния во внутренних органах.

Из-за нефункциональности или малого количества лейкоцитов у пациента снижается иммунитет. Это проявляется частыми вирусными и бактериальными инфекциями, нагноением небольших ран, лихорадкой. Повышение температуры и вялость может быть вызвана и интоксикацией организма бластными клетками. Практически в 100% случаев ОМЛ у пациентов пропадает аппетит и наблюдается быстрая потеря веса.
На начальном этапе развития болезни ОМЛ может протекать бессимптомно или неспецифично. На второй – развёрнутой – стадии наблюдается, в первую очередь, выраженный токсический синдром. Рецидивы развиваются в аналогичной последовательности.
Дополнительные признаки миелоидного лейкоза
В случае, если незрелые клетки попадают в центральную нервную систему, у больного может болеть голова, появиться рвота, нарушиться зрение и деятельность лицевых нервов. Эти проявления называют лейкозным менингитом.
При гиперлейкоцитозе и инфильтрации бластов в лёгочную ткань (лейкозной пневмонии) нарушается дыхательная функция. По статистике, такое проявление миелоидной лейкемии наблюдается у каждого четвёртого пациента.
Для миелоидной саркомы, которая составляет до 10% всех клинических случаев ОМЛ, характерны кожные проявления – плотные опухолевидные лейкемиды зеленоватого, розового, серого, белого или коричневого оттенка, нередко с воспалением кожи вокруг них.
У мужчин при ОМЛ может наблюдаться увеличение одного или обоих яичек.
Диагностика заболевания
Диагностика миелолейкоза, как правило, проводится на второй стадии заболевания, при проявлении клинических симптомов. Гематолог собирает анамнез пациента, наблюдает за динамикой изменения состава общего анализа крови и проводит пункцию костного мозга (местом забора ткани назначается грудина или гребень подвздошной кости).
Характерными изменениями на ОАК считается повышение скорости оседания эритроцитов и общего количества лейкоцитов (в 62% случаев) на фоне снижения уровня концентрации зрелых белых клеток, гемоглобина, гематокрита, ретикулоцитов, тромбоцитов и отсутствия эозинофилов и базофилов (при мутации нейтрофильного ростка).
Окончательный диагноз ставится по результатам миелограммы – количественного и качественного анализа костномозговой ткани. При миелоидном лейкозе цитохимический анализ обнаруживает положительную реакцию на миелопероксидазу и липиды, но отрицательную – на гликоген. Химический метод позволяет быстро дифференцировать ОМЛ и лимфобластный лейкоз. Вид мутантной клетки уточняют при помощи иммунофенотипирования. При ОМЛ количество незрелых клеток в костномозговой ткани составляет не менее 20%.
Для выявления характерных мутаций, которые могут повлиять на прогноз выживаемости и требуют особого подхода к лечению, проводится цитогенетическое исследование биоматериала.
Из-за того, что пролиферация незрелых лейкоцитов (и других клеток миелоидного ростка) негативно влияет на весь организм, одновременно с диагностикой белокровия проводится исследование состояния внутренних органов, костной и лимфатической системы, мозговых оболочек. Для этого используются методы УЗИ, рентгенографии, биохимических проб крови и любмальной пункции.
Лечение и прогнозы при остром миелоидном лейкозе
Несмотря на опасность заболевания, острый миелоидный лейкоз возможно излечить. При благоприятных прогнозах, отсутствии противопоказаний к трансплантации костного мозга и своевременно начатой химиотерапии риски рецидива болезни снижаются до минимальных.
Классической методикой лечения ОМЛ считается комбинация из полихимиотерапии и трансплантации стволовых клеток. Курс состоит из трёх этапов:
- Индукция (активация). Цель первого этапа – достижение полной ремиссии заболевания (снижения количества незрелых клеток в костномозговой ткани до 5% и менее). Терапия проводится препаратами цитарабина («Цитозар») и антрациклинов («Идарубицин», «Рубомицин» и др.) по схеме «5+2» или «7+3» (5-7 дней введения цитарабина, в первые 2-3 дня вместе с антрациклинами).Индукционный этап может дополняться и другими препаратами в зависимости от типа белокровия – например, ПТРК при промиелоцитарном лейкозе. Полная ремиссия наступает в 50-70% клинических случаев ОМЛ.
- Консолидация. Служит для окончательного уничтожения аномальных клеток и восстановления кроветворения. При низких рисках рецидива больным назначают 3-5 химиотерапевтических курсов и иммунотерапию, при высоких – трансплантацию костномозговой ткани от подходящего донора. Высокие риски рецидива обычно ассоциированы с цитогенетическими изменениями.
- Поддерживающая терапия. Способствует увеличению продолжительности ремиссии и включает 5-дневные ежемесячные курсы химиопрепаратов в таблетках в течение 2-5 лет.
На первых двух этапах происходит полное уничтожение бластов, поэтому для исключения побочных эффектов лечения больному проводят вливание компонентов крови, антибактериальную и деинтоксикационную терапию. Фактическое отсутствие собственного иммунитета обуславливает необходимость соблюдения стерильности условий содержания больного.

При тяжёлых нарушениях работы внутренних органов, высоком риске инфекционных осложнений и преклонном возрасте пациента вместо высокодозного курса применяют паллиативную терапию.
Средняя эффективность терапии ОМЛ составляет 20-45% в аспекте пятилетней выживаемости. Менее благоприятные, чем при лимфобластном лейкозе, прогнозы обусловлены возрастом и частотой соматических нарушений у пациентов с миелоидной лейкемией.
Комплексная диагностика – важный этап в лечении миелоидной лейкемии. Учитывая функциональность внутренних органов, цитогенетические характеристики и вид аномальных клеток при подборе лечебного курса, врач может значительно увеличить шансы на достижение стойкой ремиссии и длительную выживаемость пациента.
Published at Tue, 07 Nov 2017 07:55:27 +0000


